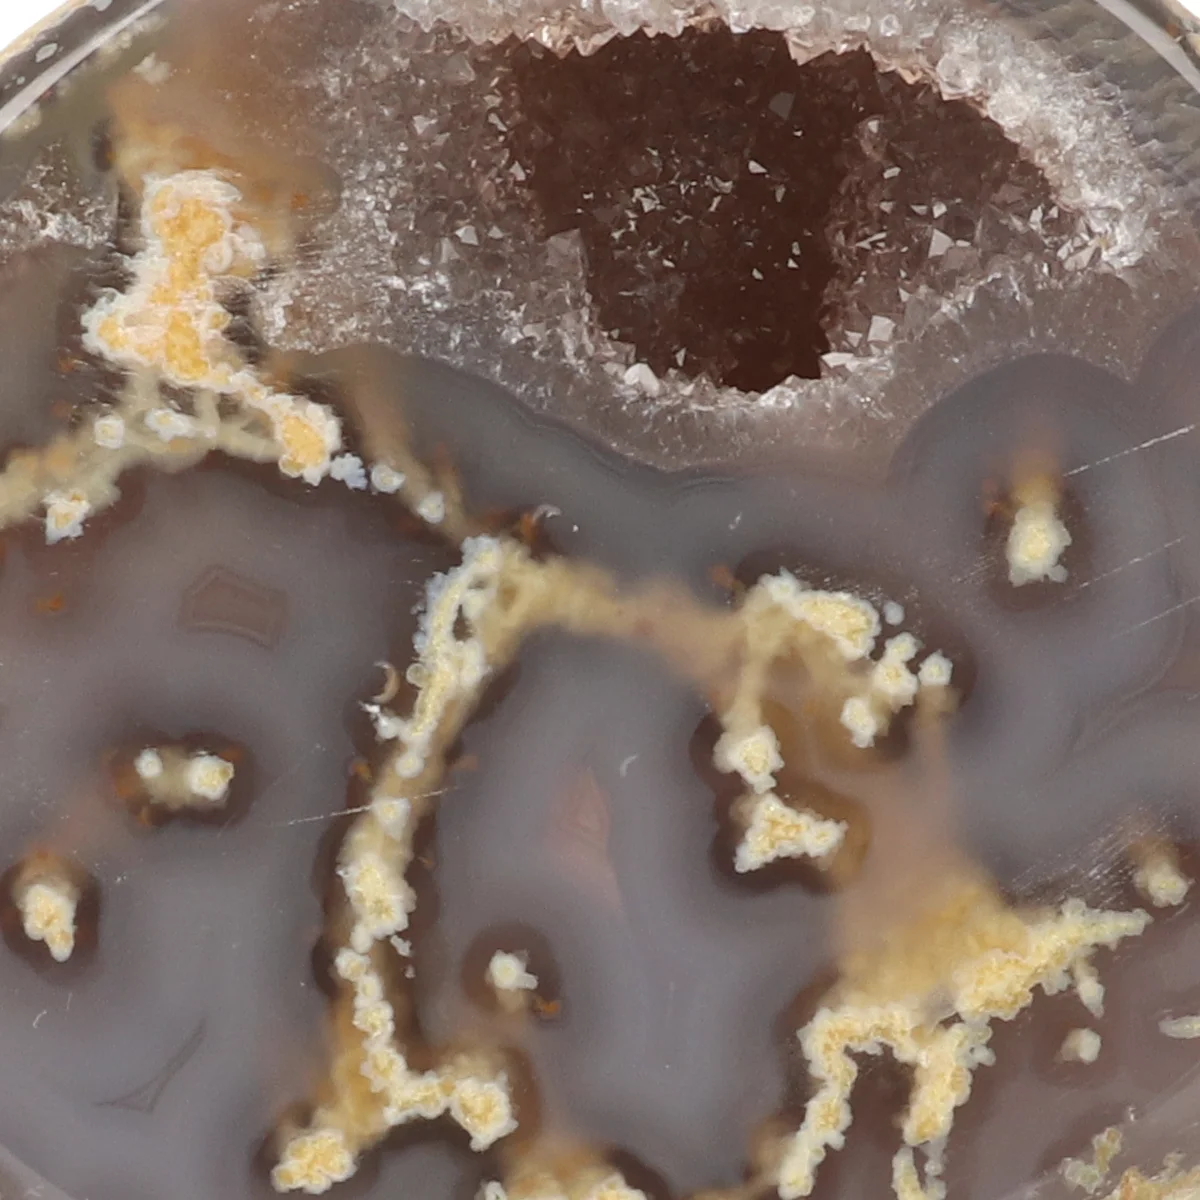
Agaat Geode op Standaard 2 Agaat Geode op Standaard uit Braziliƫ met artikelnummer 21572

| Gewicht | 0,35 kg (350 gr) |
|---|---|
| Afmetingen | 7 × 4 × 6 cm |
| Verkoopeenheid | |
| Soort | |
| Maat | |
| Vorm | |
| Herkomst | |
| Artikelnummer | 21572 |
Agaat Geode op Standaard | S
Agaat Geode op Standaard uit Brazilië
Agaat op Standaard
Deze Agaat is doorgezaagd, gepolijst en geplaatst op een zwarte gecoate standaard. Wij hebben drie varianten in ons assortiment: Agaat Geode op Standaard, Agaat Eind op Standaard en Agaat op Standaard.
Een Agaat Geode heeft doorgaans een opening met zichtbare kristalvorming. Een Agaat Eind (het eindstuk van een geode) is meestal massief en heeft geen opening, maar kan heel soms lichte kristalvorming bevatten. De Agaat op Standaard is volledig massief en oogt daardoor over het algemeen eentoniger dan een Agaat Eind.
Alle varianten zijn verkrijgbaar in maat S en M:
Maat S: hoogte 12–15 cm (inclusief standaard). De voet van de standaard is 5 × 7 cm.
Maat M: hoogte 14–17 cm (inclusief standaard). De voet van de standaard is 7 × 9 cm.
Kleine imperfecties of lichte krasjes op de zwarte standaard zijn niet altijd te voorkomen.
Agaat
Agaat is een veelkleurige variëteit van chalcedoon, die wordt gekenmerkt door zijn fijne bandstructuren en gelaagde patronen. De kleuren ontstaan door verschillende mineralen die tijdens de vorming in lagen zijn afgezet. Agaat wordt al duizenden jaren gebruikt voor sieraden en decoratie vanwege zijn aantrekkelijke uiterlijk en grote variatie in vormen.
Belangrijke vindplaatsen zijn onder andere Brazilië, Uruguay, India, de Verenigde Staten en Madagaskar. Agaat vormt zich in vulkanische gesteenten en komt vaak voor in geodes. De chemische formule is SiO₂, omdat het een vorm van kwarts is. Agaat heeft een hardheid van 6,5 tot 7 op de schaal van Mohs.
Bekende varianten: Botswana Agaat, Crazy Lace Agaat, Mosagaat en Bloem Agaat zijn enkele populaire en veelgevraagde types, elk met een eigen karakteristiek patroon en kleurstelling.
Bronnen:
Mindat.org, Gemdat.org, Wikipedia – Agaat